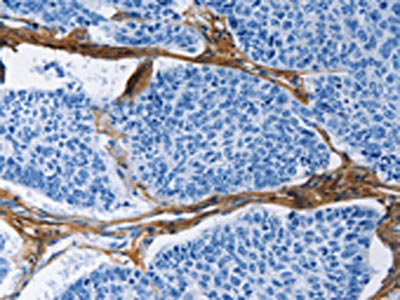

-
中文名稱:COL3A1兔多克隆抗體
-
貨號:CSB-PA125350
-
規格:¥1100
-
圖片:
-
The image on the left is immunohistochemistry of paraffin-embedded Human lung cancer tissue using CSB-PA125350(COL3A1 Antibody) at dilution 1/60, on the right is treated with fusion protein. (Original magnification: ×200)
-
The image on the left is immunohistochemistry of paraffin-embedded Human prostate cancer tissue using CSB-PA125350(COL3A1 Antibody) at dilution 1/60, on the right is treated with fusion protein. (Original magnification: ×200)
-
-
其他:
產品詳情
-
Uniprot No.:
-
基因名:
-
別名:Alpha 1 type III collagen antibody; Alpha1 (III) collagen antibody; CO3A1_HUMAN antibody; COL 3A1 antibody; COL3A1 antibody; Collagen alpha 1(III) chain antibody; Collagen alpha-1(III) chain antibody; Collagen III alpha 1 chain precursor antibody; Collagen III alpha 1 polypeptide antibody; Collagen type III alpha 1 (Ehlers Danlos syndrome type IV autosomal dominant) antibody; Collagen type III alpha 1 antibody; Collagen type III alpha 1 chain antibody; Collagen type III alpha antibody; Collagen; fetal antibody; EDS4A antibody; Ehlers Danlos syndrome type IV; autosomal dominant antibody; Fetal collagen antibody; Type III collagen antibody
-
宿主:Rabbit
-
反應種屬:Human,Mouse,Rat
-
免疫原:Fusion protein of Human COL3A1
-
免疫原種屬:Homo sapiens (Human)
-
標記方式:Non-conjugated
-
抗體亞型:IgG
-
純化方式:Antigen affinity purification
-
濃度:It differs from different batches. Please contact us to confirm it.
-
保存緩沖液:-20°C, pH7.4 PBS, 0.05% NaN3, 40% Glycerol
-
產品提供形式:Liquid
-
應用范圍:ELISA,IHC
-
推薦稀釋比:
Application Recommended Dilution ELISA 1:1000-1:5000 IHC 1:50-1:200 -
Protocols:
-
儲存條件:Upon receipt, store at -20°C or -80°C. Avoid repeated freeze.
-
貨期:Basically, we can dispatch the products out in 1-3 working days after receiving your orders. Delivery time maybe differs from different purchasing way or location, please kindly consult your local distributors for specific delivery time.
-
用途:For Research Use Only. Not for use in diagnostic or therapeutic procedures.
相關產品
靶點詳情
-
功能:Collagen type III occurs in most soft connective tissues along with type I collagen. Involved in regulation of cortical development. Is the major ligand of ADGRG1 in the developing brain and binding to ADGRG1 inhibits neuronal migration and activates the RhoA pathway by coupling ADGRG1 to GNA13 and possibly GNA12.
-
基因功能參考文獻:
- Elevated circulating PIIINP levels are associated with type 2 diabetes mellitus individuals with adipose tissue expansion and systemic proinflammatory profile suggestive for adipose tissue dysfunction. PMID: 29471595
- Reduced expression of types I and III collagen and TIMP-1 as well as the increased expression of MMP-1 and MMP-8 in the anterior vaginal wall tissues play important roles in the onset of pelvic organ prolapse. PMID: 29263043
- a variant of COL3A1 (rs3134646) is associated with the risk of developing colonic diverticulosis in white men, whereas rs1800255 (COL3A1) and rs1800012 (COL1A1) were not associated with this condition after adjusting for confounding factors. PMID: 29533249
- Brain MRI in the affected siblings as well as in the two previously reported individuals with bi-allelic COL3A1 mutations showed a brain phenotype similar to that associated with mutations in GPR56. PMID: 28258187
- Given the high specificity of the polymorphism at the rs1800255 locus of the COL3A1 gene, determined by the Sanger sequencing, it can be concluded that there is an association between this polymorphism and urinary incontinence and pelvic organ prolapse in women. PMID: 29376591
- Case Report: novel missense COL3A1 mutation in vascular Ehlers-Danlos syndrome patient presenting with pulmonary complications and iliac arterial dissection. PMID: 29216800
- Kaplan-Meir analysis of GSE7696 indicate that COL3A1 and SNAP91 correlated with survival. PMID: 27655637
- provide a picture of the gene expression changes in vascular Ehlers-Danlos syndrome skin fibroblasts and highlight that dominant negative mutations in COL3A1 also affect post-translational modifications and deposition into the ECM of several structural proteins crucial to the integrity of soft connective tissues PMID: 29346445
- We identified biallelic COL3A1 variants in two unrelated families. In a 3-year-old female with developmental delay the nonsense variant c.1282C>T, p.(Arg428*) was detected in combination the c.2057delC, p.(Pro686Leufs*105) frame shift variant. PMID: 28742248
- In conclusion, based on serological collagen formation and degradation makers, penetrating Crohn's disease is associated with increased matrix metalloproteinase-9 mediated breakdown of type III collagen PMID: 28481042
- Col3A may be a potential adjunct marker for both differentiating fibroadenoma from phyllodes tumor and assessing malignant potential in PTs. PMID: 27498063
- Case Report: pathogenetic heterozygous COL3A1 mutation c.3140 G>A, p. Gly1047Asp in Ehlers-Danlos syndrome vascular type with different phenotypes in the same family. PMID: 28183226
- von Willebrand factor A1 domain-collagen binding is independent of gain- or loss-of-function phenotype and under shear stress, platelet translocation pause times on collagen-bound A1A2A3 are either normal or shorter depending on whether A1 is concertedly bound with the A3 domain to collagen. PMID: 27889474
- High serum procollagen type III N-terminal peptide expression is associated with non-alcoholic fatty liver disease. PMID: 27442361
- The findings indicate the critical role of CatB in regulating the expression of collagens III and IV by fibroblasts via prolonging TLR2/NF-kappaB activation and oxidative stress. PMID: 27648120
- High COL3A1 expression is associated with colorectal carcinoma. PMID: 26741506
- novel missense mutation c.2176G>C in Chinese family with vascular Ehlers-Danlos syndrome PMID: 25420629
- High serum Collagen Type III is associated with ovarian and breast cancer. PMID: 26406420
- A novel missense mutation in COL3A1 was found in a young patient with cervical artery dissection as the single manifestation of Ehlers-Danlos syndrome. PMID: 26497932
- the clinical phenotype of Ehlers-Danlos syndrome patients is influenced by the type of COL3A1 variant. PMID: 25758994
- Report dysregulated expression of COL3A1 in disc degeneration. PMID: 25893343
- TGFbeta target genes including TGFBI, BAMBI, COL3A1 and SERPINE1 are significantly increased in Diamond Blackfan Anemia induced pluripotent stem cells PMID: 26258650
- The production and purification of rhCOL3A1 described in this study offer a new method for obtaining high level of rhCOL3A1 in relatively pure form, which is suitable for biomedical materials application. PMID: 25231012
- These results suggest that let-7d may suppress renal cell carcinoma growth, metastasis, and tumor macrophage infiltration at least partially through targeting COL3A1 and CCL7. PMID: 25193015
- compare reported phenotypes for patients with missense variants in the C-propeptide domain for other human collagen disorders including COL1A1 and COL1A2 (osteogenesis imperfecta). PMID: 25846194
- miR-29a and miR-29b enhance cell migration and invasion in nasopharyngeal carcinoma progression by regulating SPARC and COL3A1 gene expression. PMID: 25786138
- Data indicate that N-terminal propeptide of type III procollagen (PIIINP) is a highly effective means to evaluate left ventricular (LV) end-diastolic pressure (EDP) in patients with acute coronary syndrome (ACS). PMID: 25559610
- The first main finding of this study was that the rare COL3A1 rs1800255 AA genotype was associated with increased risk of anterior cruciate ligament injuries in the Polish cohort but not the South African cohort. PMID: 25073002
- During heart valve development, Krox20-mediated activation of fibrillar Col1a1 and Col3a1 genes is crucial to avoid postnatal degeneration of the aortic valve leaflets. PMID: 25344368
- In familial AAA we found one pathogenic and segregating variant (COL3A1 p.Arg491X), one likely pathogenic and segregating (MYH11 p.Arg254Cys), and fifteen VUS. PMID: 26017485
- rs1800255, COL3A1 2209 G>A polymorphism not associated with pelvic organ prolapse in Dutch population PMID: 24760181
- Variants of the COL3A1 gene are associated with a risk of stroke recurrence and prognosis. PMID: 24664438
- As a result of the translocations, COL3A1-PLAG1, the constitutively active promoter of the partner gene drives the ectopic expression of PLAG1. PMID: 24700772
- Gal-1 decreased the expression of collagen genes COL3A1 and COL5A1 but increased the expression of fibronectin and laminin 5. PMID: 24503541
- Arterial pathology in vascular Ehlers-Danlos syndrome individuals is related to the underlying COL3A1 mutation type. PMID: 24650746
- Expression of COL3A1 mRNA encoding key fibrotic extracellular matrix molecules was down-regulated by pre-miRNA-29b. PMID: 24641356
- The results point to the fact that the injury and/or mandible fracture increase the collagen type III metabolism and its dynamics depends on the type of the used bone fixation. PMID: 24421219
- Case Report: Ehlers-Danlos syndrome IV due to a mutation in intron 14 of the COL3A1 gene leading to venous manifestations without affecting arterial vessels at clinical presentation. PMID: 23688910
- Data suggest that cardiac fibrosis, as assessed by serum extracellular matrix protein biomarkers (including PIIINP, procollagen Type III-N-terminal peptide), develops early in hypertensive patients and is predictive of cardiovascular events or death. PMID: 22788708
- analysis of collagen folding in Vascular Ehlers-Danlos syndrome mutations PMID: 23645670
- COL3A1 rs1800255, COL6A1 rs35796750 and COL12A1 rs970547 were not significantly associated with sit-and-reach, straight leg raise or total shoulder rotation range of motion PMID: 23013106
- This study indicates that SP, mediated via NK-1 R, increases collagen remodeling and leads to increased MMP3 mRNA and protein expression that is further enhanced by cyclic mechanical loading. PMID: 22836729
- IL-17, IL-23 and PIIINP have an inverse correlation with vitamin D in their involvement in the immune response in patients with HCV-4-related liver diseases in Egypt PMID: 22851868
- study found that allele A of SNP rs1800255 conferred a 1.71-fold increased risk for intracranial aneurysms (IAs) and results in an amino acid change of Ala698Thr, which led to a lower thermal stability of the peptide; results support the view that the functional variant of COL3A1 is genetic risk factors for IAs in the Chinese population PMID: 22241462
- The minimum type III sequence necessary for cleavage by the MMP1 and MMP13 was 5 GXY triplets, including 4 residues before and 11 residues after the cleavage site (P4-P11'). PMID: 22573319
- Alveolar macrophages exposed to SiO2 can induce elevated type III procollagen and collagen III expression levels in human lung fibroblasts. PMID: 21941774
- Through alveolar macrophage mediation SiO2 can accelerate the expression of TIMP-1 and collagen III, and inhibit the expression of MMP-1 in human lung fibroblasts. PMID: 20039537
- procollagen III N-terminal peptide has a role in HBeAg loss in patients with chronic hepatitis B during entecavir therapy PMID: 22019950
- Disease-associated mutations prevent GPR56-collagen III interaction. PMID: 22238662
- Data show that homozygous and compound heterozygous changes found in PLOD1 and SLC2A10 may confer autosomal recessive effects, and three MYH11, ACTA2 and COL3A1 heterozygous variants were considered as putative pathogenic gene alterations. PMID: 22001912
顯示更多
收起更多
-
相關疾病:Ehlers-Danlos syndrome 3 (EDS3); Ehlers-Danlos syndrome 4 (EDS4)
-
亞細胞定位:Secreted, extracellular space, extracellular matrix.
-
蛋白家族:Fibrillar collagen family
-
數據庫鏈接:
Most popular with customers
-
-
YWHAB Recombinant Monoclonal Antibody
Applications: ELISA, WB, IHC, IF, FC
Species Reactivity: Human, Mouse, Rat
-
Phospho-YAP1 (S127) Recombinant Monoclonal Antibody
Applications: ELISA, WB, IHC
Species Reactivity: Human
-
-
-
-
-